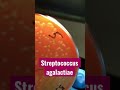

ЧТО ВКЛЮЧАЕТ В СЕБЯ 1 СКРИНИНГ ПРИ БЕРЕМЕННОСТИ
1 скрининг при беременности - это один из важных этапов пренатального скрининга, который позволяет определить вероятность развития некоторых генетических и хромосомных нарушений у плода.
Обычно 1 скрининг проводят в период от 11 до 14 недель беременности. Во время данного скрининга осуществляются несколько процедур:
1. УЗИ - это неинвазивное и безопасное исследование, которое позволяет определить структуру и развитие плода. Врач измеряет толщину "клетчатки" на затылочной области плода, а также осматривает органы и системы для выявления возможных аномалий.
2. Кровь матери анализируется на наличие двух биомаркеров: белка PAPP-A и гормона hCG. Эти показатели позволяют оценить риск развития хромосомных нарушений.
Результаты 1 скрининга обрабатываются вместе с возрастом матери, весом, ростом и другими факторами, чтобы определить вероятность наличия хромосомных аномалий у плода. Врач может сделать выводы о возможной необходимости дальнейших исследований, таких как амниоцентез или хорионическая биопсия.
Необходимо отметить, что 1 скрининг при беременности не является окончательным диагнозом, а лишь показывает вероятность возникновения проблем. Поэтому, в случае выявления высокого риска, вам могут быть предложены более точные методы диагностики для получения более точных результатов.
Патологические изменения плода, выявляемые при скрининге 1-го триместра беременности
Ведение беременности. Первый скрининг
Скрининг первого триместра - Людмила Шупенюк и Волык Нелла
Что включает в себя «Скрининг 1 триместра»?
Скрининг 1-го триместра беременности
Первый скрининг при беременности. Как проходит первый скрининг (скрининг первого триместра) в ЦИР.
Скрининг 1 триместра: сроки проведения и что показывает первый скрининг при беременности